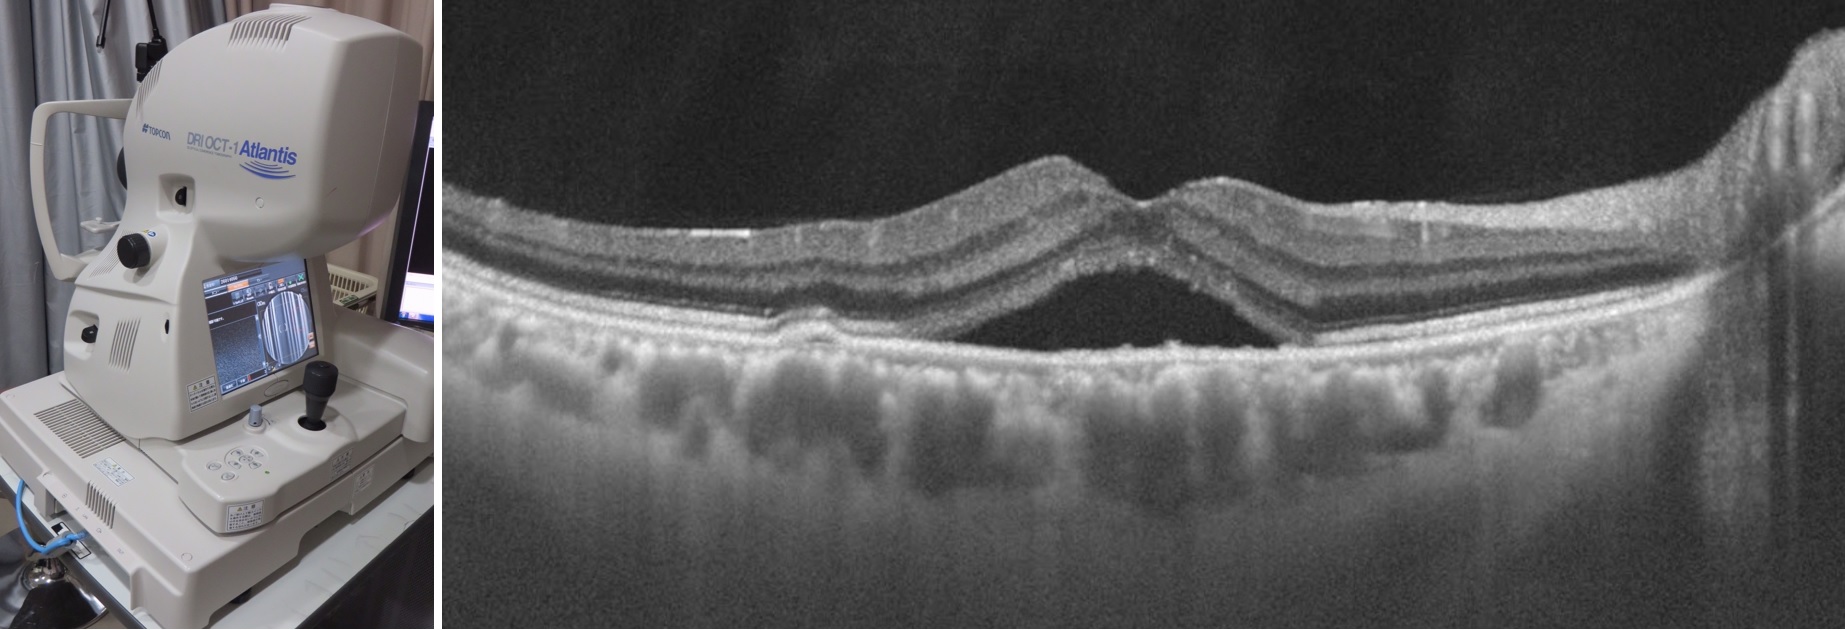
Photo_黄斑外来_No.2

黄斑・網膜硝子体外来


ただし、半径3mm円程度の大きさに過ぎません。その小さな範囲に障害が生じれば、それは即座に視力低下をきたすことを意味します。10年ほど前までは眼科医にとって触れることのできない場所でした。近年、医療機器の進歩に伴い、この黄斑部の形態学的・機能的な特徴が次々と明らかになり、現在ではその治療も可能となってきています。

患者の集中する黄斑・網膜硝子体外来は月曜日、水曜日、木曜日で、その両日とも新宿区や都内からだけでなく、関東から時には東北や関西からの患者で終日混雑しています。特に紹介患者が多いのも黄斑・網膜硝子体外来の特徴で、連日一般病院の眼科では見ることのできない特殊な症例がたくさん集まってきています。

網膜の画像検査に関しては蛍光眼底造影検査が一般的ですが、造影剤を使用しなければなりません。最近ではより侵襲の少ない検査が望まれており、黄斑部形態を非侵襲的に可視化し評価できる装置として光干渉断層計(OCT)が注目されています。当科では網膜だけでなく脈絡膜・強膜などの眼底深部まで観察できる高侵達OCTをプロトタイプ機、つまり開発段階から全国に先駆けて使用していました。さらに、黄斑部の形態評価だけでなく機能的な評価のために当科では非侵襲的に視細胞および網膜色素上皮細胞機能を評価できる眼底自発蛍光検査に関しても研究レベルの時代から注目し、活用していました。現在は一般な装置だけでなく当科にしかない先進的な装置を含めて3種類、計4台が稼働中で、これを使って日々の診療および研究を行っています。さらに、これから視細胞そのものを宇宙科学の補償光学技術を応用して可視化できる最新の眼底検査機器も導入予定です。上記以外の様々な装置も使用することで、他では見ること、知ることのできない情報から黄斑部疾患の診断・研究を行い、数多くの新たな知見を学会や欧文雑誌に報告しています。

特に滲出型加齢黄斑変性は、脈絡膜新生血管が黄斑部に生じる疾患で、2008年から抗VEGF(血管内皮増殖因子)剤の硝子体注射によって治療可能となり視力回復も期待できるようになりました。当科では急増する加齢黄斑変性患者に対応するため2013年7月に外来を拡張し、硝子体注射専用の施設として黄斑ケアユニットを開設しました(詳細は別項参照)。2014年3月現在の硝子体注射の数は前年比で倍増しています。もちろん加齢黄斑変性以外にも、中心性漿液性脈絡網膜症、網膜静脈閉塞症、近視性黄斑症、網膜色素線条など各種黄斑疾患に対する診療および治療を行っています。

具体的には黄斑前膜・黄斑円孔・糖尿病黄斑症、黄斑分離症などはもちろん裂孔原性網膜剥離や眼球破裂などの救急疾患には時間外でも対応しています。
つまり、当科の黄斑・網膜硝子体外来はmedicalやsurgicalに偏ることのない広い知識や経験を持った黄斑部のスペシャリストで構成されており、受診される患者はもちろん、これから黄斑疾患・網膜硝子体疾患を学ぼうとする若い眼科医たちにとっても十分満足出来る環境が整っています。
<担当専門医> 飯田 知弘、丸子 一朗、長谷川 泰司、丸子 留佳、荒川 久弥、和泉 雄彦、河合 萌子
<外来診療日> 月曜日・水曜日・木曜日 午前午後
眼循環外来
平成25年4月より新たに開設した専門外来です。眼の血流循環障害を専門とした本邦でも珍しい専門外来です。代表的な疾患は、網膜静脈閉塞症(中心、分枝)、網膜動脈閉塞症(中心、分枝)、眼虚血症候群、内頚動脈閉塞症、腎性網膜症(高血圧、貧血)、一過性黒内障などで、眼および全身の循環障害による病態を専門にしております。
眼は組織あたりの血流量が、体中で最も多い器官です。人間の卓越した視機能を保持するためには、豊富は血流が必要だからです。従って、眼の血流動態に僅かでも異常が生じると、人は敏感に視力障害として認識します。多くの場合、眼の循環障害では、中心視野が侵されるので患者様は非常に苦痛を感じます。
我々は、従来からある造影検査(フルオレセインナトリウム・インドシアニングリーン)は勿論の事、最新の高侵達光干渉断層計(OCT)、自発蛍光、本邦で開発され2009年に保険収載されたばかりの新しい血流検査機器である、レーザースペックルフローグラフィー(LSFG-NAVI)などを総合的に駆使し、眼循環障害を多角的に診断し、患者様それぞれのニーズにあったオーダーメードの治療を心掛けております。
特に、LSFG-NAVIに関しての研究は活発に行っており、国内外の学会・研究会で発表・討論を行い、より良い治療について日々模索をしております。

また、治療面では、従来からのレーザー治療、硝子体手術に加え、抗VEGF阻害薬硝子体内注射による治療を積極的に行っております。抗VEGF阻害薬硝子体内注射は、網膜静脈閉塞症に併発する黄斑浮腫に対して認可されている治療です。多くの方が数回の注射を必要としますが、我々は国際的な大規模コントロールスタディーを参考に、当院独自の注射方法を用い、患者様が最小の負担で最大限の効果を得て頂けるように工夫をしています。静脈閉塞症の患者様はご高齢の方が中心で、多くの場合白内障を合併していることがあります。我々は、少しでも早く患者様に視力改善を自覚して頂くよう、「水晶体再建術(白内障手術)併施の抗VEGF抗体硝子体内注射」を日帰り手術で積極的に行っており、良好な結果を得ております。
今後も、患者様に治療効果を実感していただけるよう、詳細な研究に基づいた治療方針を検討してまいります。
ドライアイ外来
 ドライアイは様々な要因により、涙液と眼表面の粘膜が障害をうけ、目の不快感が続く疾患です。
ドライアイを引き起こすリスクファクターをつきとめ治療を継続することで、症状を改善することができます。
ドライアイは様々な要因により、涙液と眼表面の粘膜が障害をうけ、目の不快感が続く疾患です。
ドライアイを引き起こすリスクファクターをつきとめ治療を継続することで、症状を改善することができます。
<担当専門医>高村 悦子、篠崎 和美
<外来診療日>火曜日午後(第2・4週)
未熟児網膜症外来
近年、周産期医療の発達により超低出生体重児の生存率が大きく改善しております。
予定より早く生まれた赤ちゃんは網膜の血管が途中で止まってしまっていることがあり、失明につながる病気になることがあります。これを未熟児網膜症といいます。NICU往診により眼底検査を行い、未熟児網膜症のスクリーニングを行います。未熟児網膜症を発症した場合、定期的な診察をしてゆきます。自然に治る場合もありますが、病状が強い時には治療が必要になります。未熟児網膜症を発症した赤ちゃんはNICU退院をしたあと、未熟児外来で定期的な診察をしてゆきます。
<担当専門医>丸子 一朗
<外来診療日>火曜日午前

角膜外来
 目の大切な働き「視覚」。これは、透明な角膜を通して、目に光が入ってくることで始まります。
細菌やウイルスなどの感染症、アレルギー、変性症など角膜におこる疾患の診療を行っています。
目の大切な働き「視覚」。これは、透明な角膜を通して、目に光が入ってくることで始まります。
細菌やウイルスなどの感染症、アレルギー、変性症など角膜におこる疾患の診療を行っています。
<担当専門医>高村 悦子、篠崎 和美、木全 奈都子、田尻 晶子
<外来診療日>水曜日午後
色覚外来
色覚異常には、先天色覚異常と後天色覚異常があります。先天色覚異常は遺伝による錐体視物質の異常でX連鎖性遺伝(伴性劣性遺伝)をし,日本人では男性の約5%,女性の約0.2%に見られます。それ以外の原因,たとえば目や脳内の病気などによる色覚障害を後天色覚異常といいます。
 先天赤緑色覚異常では隣り合った色などが見分けにくいことがあります。見分けにくい色の組み合わせ例は表1の通りです。いつも間違えるわけではありません。その色の面積が小さいとき,色の彩度や明度が低いとき,ちらっと見ただけのとき,疲れているとき,などに誤りやすいものです。反対に,注意深く見たときには間違えることが少ないので,とくに仕事で必要なときには,ご本人がどの色を誤りやすいか自覚していることが大切です。
先天赤緑色覚異常では隣り合った色などが見分けにくいことがあります。見分けにくい色の組み合わせ例は表1の通りです。いつも間違えるわけではありません。その色の面積が小さいとき,色の彩度や明度が低いとき,ちらっと見ただけのとき,疲れているとき,などに誤りやすいものです。反対に,注意深く見たときには間違えることが少ないので,とくに仕事で必要なときには,ご本人がどの色を誤りやすいか自覚していることが大切です。
しかし,先天色覚異常の人にとってその見え方は生涯変わらず,他人の見え方を実感することもできません。そのため自分が色を間違っているという自覚が非常に少なく,誤った場合でも自らそれを具体的に表現しなければ周囲に気づかれることもありません。そのため色覚異常の事実をご本人も周囲も知らないままに,学業や仕事の上で思わぬ困難や不利益を生じることがあります。
現在では,進学時に色覚異常のために入学を拒まれることはほとんどなくなっていますが,就職時などには,制限を受ける職種がいくつかあり,また制限を受けない職種でも,自らの色覚の状態を知り,自覚をもって行動することはとても大切です。
色覚外来は全国でも数少なく,なかでも当院は,自らも先天色覚異常の保因者である担当医が,色覚異常の具体的な色の見えについての研究にもとづき,当事者の立場で親身に相談に応じることで知られています。
まず,受診者様の色覚の型と程度を正しく診断し,その上で,どのように色を間違えやすいか説明し,生活や学業・職業にどのように影響するか,またその対策はどうたてるかなどについてカウンセリングを行っています。また,必要に応じ,支障の程度を盛り込んだ診断書を発行しています。
 後天色覚異常は網膜や視神経,大脳などのさまざまな病気が原因となるものをいい,色覚異常のほかに視力低下や視野障害など,原疾患による視機能障害も生じます。左右の眼で程度が異なったり,病状の悪化や改善に伴って,色覚も変化したりします。
後天色覚異常は網膜や視神経,大脳などのさまざまな病気が原因となるものをいい,色覚異常のほかに視力低下や視野障害など,原疾患による視機能障害も生じます。左右の眼で程度が異なったり,病状の悪化や改善に伴って,色覚も変化したりします。
原疾患による視機能障害が問題となり,後天色覚異常の問題はあまり目立たないことも多いのですが,人生半ばで色の感覚が変わるため戸惑うこともあります。
当色覚外来では,患者様の担当医と連携し,後天色覚異常の程度や進行度などの評価を行うとともに,どのように色を間違えやすいか,生活上注意すべきことなどの助言も行っています。
<担当専門医>中村 かおる
<外来診療日>水曜日午後
ぶどう膜炎外来
 ぶどう膜炎とは眼の中に炎症を起こす病気の総称です。ベーチェット病、サルコイドーシス、Vogt-小柳-原田病等の病気が、非感染性のぶどう膜炎の代表的な原因疾患です。また、ヘルペスウイルス、サイトメガロウイルス、結核等の感染性のぶどう膜炎も頻度はすくないですが原因疾患として注目されています。
ぶどう膜炎とは眼の中に炎症を起こす病気の総称です。ベーチェット病、サルコイドーシス、Vogt-小柳-原田病等の病気が、非感染性のぶどう膜炎の代表的な原因疾患です。また、ヘルペスウイルス、サイトメガロウイルス、結核等の感染性のぶどう膜炎も頻度はすくないですが原因疾患として注目されています。
ぶどう膜炎は目の充血、霧視(目のかすみ)、飛蚊症(目の前に細かい塵状の影が見える)といった症状から始まります。炎症を放置してしまうと、視機能が障害され失明にいたることもあるので、疾患に適した早期の治療が必要となります。
当科のぶどう膜外来では、多彩なぶどう膜炎の経験を有し、迅速な確定診断に努め、適切な治療を提供できるように心がけています。最新の治療も積極的に導入しており、難治性の非感染性ぶどう膜炎に対しても、副腎皮質ステロイド薬に加えて免疫抑制剤による治療を行い、ベーチェット病に対しては生物学的製剤(抗TNFα製剤:レミケードR)の使用も行っています。
ぶどう膜専門外来は木曜日午後ですが、初診は午前の一般外来で随時対応しています。
<担当専門医> 豊口 光子、内村 英子
<外来診療日> 水曜日午後
斜視弱視外来
 斜視弱視外来は、「目の位置がずれている」あるいは「物が2つにみえる」とういうような眼の位置(眼位)の異常が疑われる方、「学校検診の視力検査でよく見えなかった」あるいは「見えているか不安を感じる」とういうような視力の異常が疑われる乳幼児や学童のお子さんが受診する対象となっている外来です。
斜視弱視外来は、「目の位置がずれている」あるいは「物が2つにみえる」とういうような眼の位置(眼位)の異常が疑われる方、「学校検診の視力検査でよく見えなかった」あるいは「見えているか不安を感じる」とういうような視力の異常が疑われる乳幼児や学童のお子さんが受診する対象となっている外来です。
斜視は先天性のものや、生後6ヶ月以降に発症する後天性のものがあります。斜視が存在すると視力の発達および両目で物を見る能力(両眼視)の発達の妨げになることがあります。視力は1~2歳までの発達が顕著であり、物を立体的にみるのに必要な両眼視は生後3~4ヵ月ごろから発達が始まり、4歳ぐらいには完成するとされています。したがって、適切な時期に正しい診断のうえ治療を開始する必要があります。
斜視弱視外来では、斜視、屈折異常、弱視および眼球運動障害に対して視機能の正しい評価を行い、長期にわたりよい状態を維持することを目標として治療を医師と視能訓練士が緊密な連携をとりながら行っています。特に乳幼児の検査は大変根気がいる検査や診察が必要となり、時間を要するものです。経験豊かな視能訓練士が医師の指示の元、視機能、両眼視機能を伸ばすための検査や訓練を行っています。
<担当専門医> 梶本 美智子(第2および第4金曜日)、大須賀 方子(第3金曜日)、林 殿宣(第1金曜日)
<外来診療日> 金曜日午後(※第5金曜日は休診)
ロービジョン外来
医学には可能性と限界があります。様々な治療を施したにもかかわらず、ロービジョンになることがあります。
不便で残念なことです。しかしながら、失明とは異なります。ロービジョンでも残存した視力は貴重です。視能訓練士、諸施設と連携をとり、残存した視機能を少しでも有効に活用できる方法を見出して、QOLの向上のお手伝いができればと思います。
緑内障外来
緑内障外来は小暮俊介を中心に毎週火曜日の午後に診療を行っております。緑内障の中でも、眼圧コントロール不良例や後期緑内障など比較的重症な方が多く通院されています。また、近視眼や視神経乳頭部分低形成などによる視野障害との鑑別診断や、難治緑内障の治療方針決定のためにご紹介を頂く事も多いです。
緑内障は本邦における失明原因の第一位となりましたが、我々はその病因の一つとして考えられている循環障害説について、レーザースペックルフローグラフィーを用いた研究に取り組んでおります。多くの学会、研究会で活発に発表および討論をし、日々の診療へのフィードバックに努めております。
治療としましては、点眼治療は勿論の事、幅広いレーザー治療および観血的手術も積極的に行い良好な成績を収めております。
ご紹介頂きました患者様につきましては、ご紹介元の先生方との連携を心掛けております。診断、治療に迷われるような重症例でお困りの先生方、ご自身が緑内障かもしれないとご不安をお持ちの患者は、当専門外来までお気軽にご相談下さい。
<担当専門医> 小暮 俊介、三宮 瞳、出雲 令子
<外来診療日> 火曜日午後

神経眼科外来
眼を支配している神経とそれに関連した多種の疾患を扱う専門外来です。単純に表現すると、眼球の周囲や頭蓋内に生じて見え方に悪影響を与える病気を扱う専門外来です。月曜日午後に診療しています。
大きく分けると2種類の対象分野があります。
ひとつつは眼を動かす神経系です。物が2つに見える(複視)、視線がずれている、目やまぶたの動きがおかしい、といった患者さんを対象にしています。神経や筋肉の麻痺により、黒目を動かす力が低下すると、左右の視線にずれが生じますので、物が2つに見えてしまいます(複視)。種々の病気で複視を生じますが、それに対する診断と治療(手術を含む)を行っております。
もうひとつは、視神経の病気です。視力・視野に異常があるが眼球内には異常が見つからない疾患などが対象となります。具体的には、視神経の炎症(視神経炎)、視神経を栄養している血管の障害(虚血性視神経症)や視神経を圧迫して傷害する脳腫瘍などがあります。
眼科で診断がついても、治療が眼科では難しい場合もありますので、他科との協力の下に診療を進めさせていただきます。







